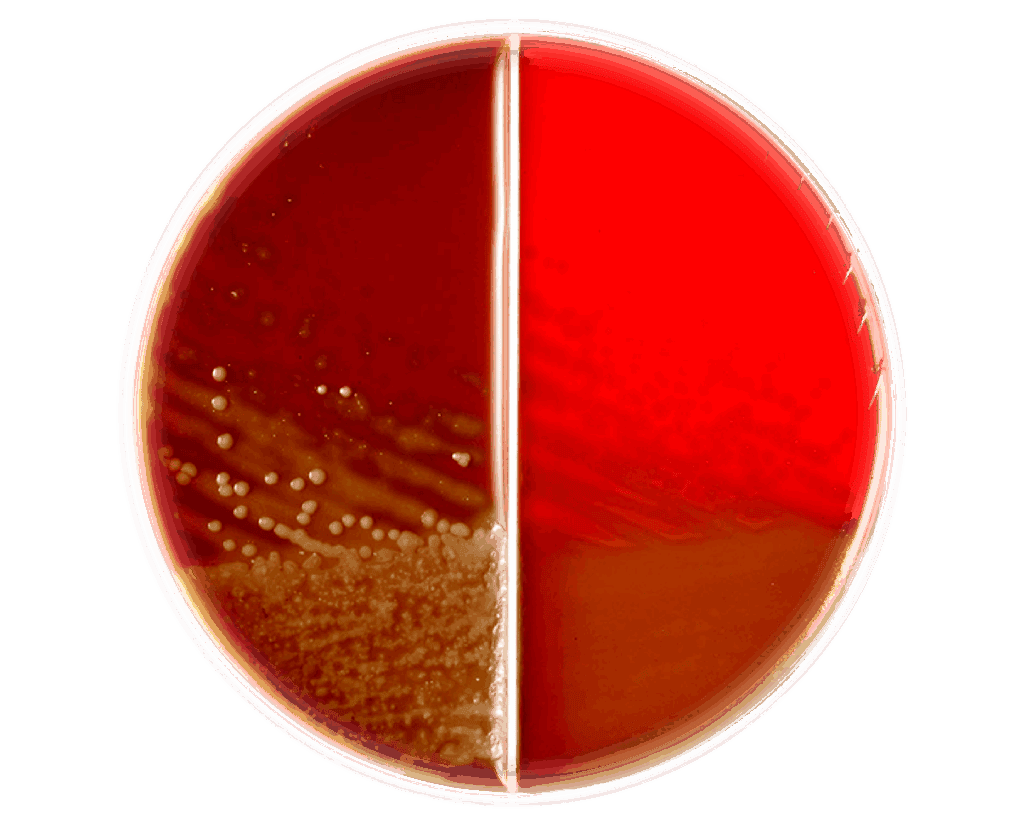

香港心兒科濕疹部門引進國際上不同的儀器窺探出孩子皮膚屏障的問題,了解皮膚底層發炎的情況更引入國際上大部份的治療方法以系統化、可量度化及證據化的基礎底下提供最大化的濕疹治療方案。





PART 1
為何濕疹容易復發?
PART 2
如何判斷濕疹治療進度、窺探出皮膚下的發炎情況,皮膚屏障及水分流失情況

PART 3
國際上其實已經有標準化規程來量度濕疹的嚴重性,對症下藥
PART 4
除了類固醇外,
有否更有效治療
PART 5
濕疹誤診,可導致嚴重併發症,
甚至有死亡風險
PART 6
濕敷療法 (Wet Wraps Therapy) 、光學治療 Phototherapy、生物製劑及TCS 外用類固醇(國際上從POTENTENCY, 分7級別)、TCI 和 PDE4 抑製劑、脫敏治療在濕疹治療中的不同應用
PART 7
濕疹確診條件



我們引進不同的儀器,目標窺探出皮膚底層的狀況,包括皮膚屏障問題及水份流失的問題,從而對症下藥。






Electrical Impedance Spectroscopy(EIS) 從電阻的反饋, 有效地了解皮膚屏障分析絲聚蛋白(filaggrin, FLG)缺失情況。
在確定皮膚屏障受損的非病變性濕疹(non lesional eczema)後,我們能夠繼續並提供足夠的皮膚屏障修復(skin barrier repair)。大大減少了疾病的復發和類固醇的需要。














濕敷療法的有效做法,是把保濕成分以及藥物密封在患處,因此同時可以做到減少皮膚水分散失、阻隔外界刺激搔抓以及幫助藥物吸收的效果。
光學治療是指透過紫外線(UV)的能量,局部抑制過分活躍的皮膚免疫系統,有效治療如濕疹等的發炎性皮膚病。光學治療可分為UV-A和UV-B療程,一般中度至嚴重的濕疹病患者,可透過Narrow band UVB療程有效控制病情, 療程一般為每週 2-3 次,持續約 3 個月。

PDE4 inhibitor – Crisaborole (Staquis)能透過抑制體內的細胞信息傳遞,進而影響一系列的分子生物學反應,使發炎反應下降。因此,Crisaborole (Staquis)比傳統類固醇能夠更精準的抑制部分發炎反應,因此造成的副作用也相對較少。
DUPIXENT是首個獲美國FDA認可,其原理是從皮膚裡面控制發炎,主要通過抑制兩種關鍵的蛋白,白細胞介素-4 (interleukin-4)和白細胞介素-13 (interleukin-13), 阻止它們所誘發的炎症反應。
Protopic 含活性成份Tacrolimus,能有效抑制患者過度活躍的T細胞數目,從而控制炎症。

類固醇藥物已有數百個醫學文獻詳細分析他的成效和可能的併發症。因此在現今醫學昌明的情況下,所有國際醫學權威也指出外用類固醇為FIRST LINE treatment。 所以家長可放心根據專業人士安全使用。

SLIT的原理是把微量的致敏原抽取物以舌底方式吸收,劑量循序漸進地增加,使身體免疫系統慢慢適應,杜絕過敏症狀。





「濕疹」大致上是指異位性皮膚炎Atopic Dermatitis (AD),症狀為痕癢、紅腫、出水以及皮膚龜裂,嬰幼兒中一般常見影響的位置是頭部面部和四肢伸肌面(extensor surface),兒童及青少年多為四肢,皮膚摺位例如手肘內側和膝蓋後方(flexural region)。較嚴重病者或會全身發作,痕癢難耐。


香港心兒科濕疹部門引進國際上不同的儀器窺探出孩子皮膚屏障的問題,了解皮膚底層發炎的情況更引入國際上大部份的治療方法以系統化、可量度化及證據化的基礎底下提供最大化的濕疹治療方案。







PART 1
為何濕疹容易復發?
PART 2
如何判斷
濕疹治療進度、
窺探出皮膚下的發炎情況、
皮膚屏障及
水分流失情況
PART 3
國際上其實已經有標準化規程來量度濕疹的嚴重性,對症下藥
PART 4
除了類固醇外,有否更有效治療
PART 5
濕疹誤診,可導致嚴重併發症,
甚至有死亡風險
PART 6
濕敷療法 (Wet Wraps Therapy) 、光學治療 Phototherapy、生物製劑及TCS 外用類固醇(國際上從POTENTENCY, 分7級別)、TCI 和 PDE4 抑製劑、脫敏治療在濕疹治療中的不同應用
PART 7
濕疹確診條件

容易復發?

很多家長為小朋友的濕疹問題而困擾,中醫、西醫、保健品也嘗試,始終藥石無靈,不能斷尾。

很多家長也苦惱,小朋友濕疹復發問題,常用皮膚藥膏只能發揮短期效果,好可能係小朋友皮膚屏障的問題,要照清皮膚底下的發炎情況才能好好根治。如果不清楚,皮下的發炎情況,根本無法對症下藥。

另外,皮膚水份流失的情況,直接影響濕疹的治療進度。但傳統的治療也不能準確,理解實際情況導致病情反覆。



如何判斷


有標準化規程
來量度濕疹的嚴重性,
對症下藥
SCORAD (指數)
SCORAD (指數)是濕疹 (特異性皮炎)中經過驗證的最佳評分系統之一,歐洲濕疹治療指引,香港兒科學會最新指引,建議使用SCORAD決定治療方針。
濕疹嚴重性?
往往看醫生的時候,診症時間短,未能充分細化皮膚嚴重程度,未能精準選取治療方針。




有否更有效治療




可導致嚴重併發症,
甚至有死亡風險
兒科醫生的重要性
金黃葡萄球菌
兒科醫生排查病理,
防止併發症發生
由於小朋友的免疫系統未發展完善,除了一般異位性皮膚炎外,更有可能出現常見的併發症,包括金黃葡萄球菌感染,由於其表徵跟濕疹接近,當中兒科醫生必須排查病理,防止併發症發生。







濕敷療法的有效做法,是把保濕成分以及藥物密封在患處,因此同時可以做到減少皮膚水分散失、阻隔外界刺激搔抓以及幫助藥物吸收的效果。

光學治療是指透過紫外線(UV)的能量,局部抑制過分活躍的皮膚免疫系統,有效治療如濕疹等的發炎性皮膚病。光學治療可分為UV-A和UV-B療程,一般中度至嚴重的濕疹病患者,可透過Narrow band UVB療程有效控制病情, 療程一般為每週 2-3 次,持續約 3 個月。

PDE4 inhibitor – Crisaborole (Staquis)能透過抑制體內的細胞信息傳遞,進而影響一系列的分子生物學反應,使發炎反應下降。因此,Crisaborole (Staquis)比傳統類固醇能夠更精準的抑制部分發炎反應,因此造成的副作用也相對較少。

DUPIXENT是首個獲美國FDA認可,其原理是從皮膚裡面控制發炎,主要通過抑制兩種關鍵的蛋白,白細胞介素-4 (interleukin-4)和白細胞介素-13 (interleukin-13), 阻止它們所誘發的炎症反應。

Protopic 含活性成份Tacrolimus,能有效抑制患者過度活躍的T細胞數目,從而控制炎症。

類固醇藥物已有數百個醫學文獻詳細分析他的成效和可能的併發症。因此在現今醫學昌明的情況下,所有國際醫學權威也指出外用類固醇為FIRST LINE treatment。 所以家長可放心根據專業人士安全使用。

SLIT的原理是把微量的致敏原抽取物以舌底方式吸收,劑量循序漸進地增加,使身體免疫系統慢慢適應,杜絕過敏症狀。






















































